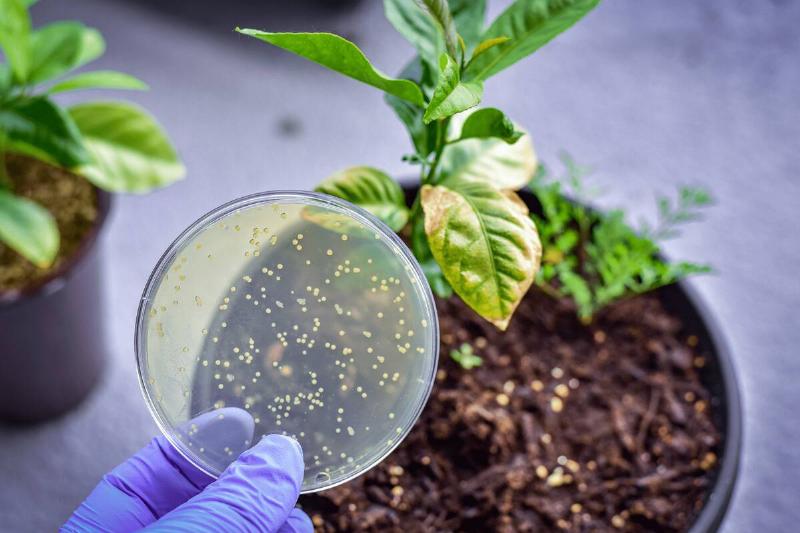

Six Ways Cinnamon Can Support Your Plants’ Growth to Enhance Your Garden
Gardening enthusiasts are always on the lookout for natural and effective ways to boost the health and growth of their plants. While many focus on fertilizers, compost, and watering routines, there's an often-overlooked spice sitting right in your kitchen that can work wonders for your garden: cinnamon. This aromatic spice, known for its culinary uses, has several beneficial properties that can help your plants thrive.
Rich in antifungal, antibacterial, and insect-repellent qualities, cinnamon can address a variety of common gardening problems. Whether you're dealing with fungus, pests, or struggling to root new plants, cinnamon offers a multi-faceted solution. Not only is it a natural and eco-friendly option, but it's also a cost-effective way to enhance your gardening practices. Here are six ways you can incorporate cinnamon into your gardening routine to ensure your plants flourish.
Combatting Fungal Infections
Fungal infections can be a significant threat to your plants' health, often causing diseases that can spread rapidly and be challenging to control. Cinnamon's antifungal properties make it a potent tool in combating these issues. By sprinkling cinnamon powder directly onto the soil or affected areas, you can inhibit the growth of fungi, such as damping-off disease that commonly affects seedlings.
This simple step can save young plants from early death and help them establish strong roots. For best results, dust the cinnamon powder lightly over the soil surface, focusing on areas where you notice mold or fungal growth. You can also create a cinnamon tea by steeping cinnamon sticks in water and using it as a spray to cover larger areas affected by fungal infections.
Preventing Damping-Off Disease

Damping-off disease is a gardener’s nightmare, particularly for those growing plants from seeds. This disease, caused by various soil-borne fungi, results in the rotting of seeds and seedlings, leading to poor germination rates and plant losses. Cinnamon can act as a natural preventative measure against damping-off.
After sowing seeds, dusting a thin layer of cinnamon on the soil surface can create a barrier that deters the fungi responsible for this condition. This protection is crucial during the early stages of plant growth when seedlings are most vulnerable. By employing this method, gardeners can improve their chances of successful seed germination and healthy seedling development.
Rooting Hormone Alternative

Plant propagation through cuttings can be tricky, often requiring the use of commercial rooting hormones to encourage root development. However, cinnamon serves as an excellent natural alternative. When you dip the cut ends of plant cuttings into cinnamon powder before planting them in soil or a growing medium, it helps stimulate root growth.
The antimicrobial properties of cinnamon also protect the cuttings from infections that could hinder their development. This natural rooting hormone is not only safer for the environment but also reduces the need for synthetic chemicals, making it a preferred choice for organic gardeners.
Repelling Insects

Insects and pests can wreak havoc on a garden, damaging plants and reducing yields. Cinnamon can be an effective natural repellent for a variety of common garden pests. Sprinkling cinnamon around the base of plants or creating a cinnamon barrier can deter ants, aphids, and other insects.
The strong scent of cinnamon confuses and repels these pests, keeping them away from your plants. For an added layer of protection, you can mix cinnamon powder with water and spray it directly onto plant leaves, stems, and soil. This not only helps in repelling insects but also adds a pleasant aroma to your garden.
Healing Plant Wounds

Plants, much like humans, can suffer from wounds caused by pruning, accidental damage, or pest attacks. These wounds can become entry points for diseases and infections if not treated properly. Cinnamon powder can act as a natural antiseptic for plant wounds. Applying cinnamon to the injured area helps to dry out the wound and prevent infection, promoting faster healing.
This treatment is especially useful for larger cuts and breaks that occur during pruning. By using cinnamon to treat plant wounds, gardeners can ensure their plants recover quickly and continue to thrive.
Deterring Furry Intruders

Gardeners often face challenges not only from insects but also from larger pests such as rabbits and squirrels. These furry intruders can cause significant damage by digging up plants and eating produce. Cinnamon's strong scent can deter these animals from venturing into your garden.
Sprinkling cinnamon powder around the perimeter of your garden beds creates a natural barrier that discourages these animals from entering. You can also mix cinnamon with other strong-smelling substances like peppermint oil for a more potent deterrent. This humane and natural method helps protect your garden without harming the animals.
Incorporating cinnamon into your gardening routine can provide a multitude of benefits, from protecting against fungal infections to deterring pests. This versatile spice is not only a natural and eco-friendly solution but also an affordable way to enhance the health and vitality of your plants. By leveraging the powerful properties of cinnamon, gardeners can create a thriving and resilient garden.
